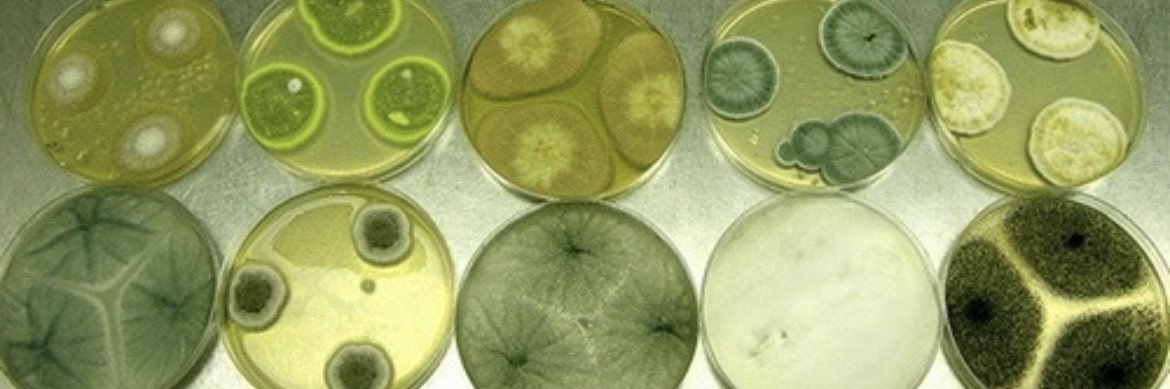
king baby ⋆｡°✩ banner

king baby ⋆。°✩ retweetledi
king baby ⋆。°✩
16.2K posts

king baby ⋆。°✩ retweetledi
king baby ⋆。°✩ retweetledi

cover girrrrrlz!!!
baby Rocki served sumn serious on her first cover! came on set and shut her mama dowwwnn!!!! @wmag 🥹💞
Photography: Tim Walker
Styling: Jahleel Weaver
Editor in Chief: Sara Moonves
Creative Directors at Large: Kevin Tekinel and Charles Levai
Writer: Maxine Wally
Hair: Mustafa Yanaz using Fenty Hair
Makeup: Daniel Sällström using Fenty Beauty & Fenty Skin
Nails: Jenny Longworth
Set Design: Miguel Bento
Movement Director: Pat Boguslawski
Production: 138 Productions
Special Thanks to DJ Andy and Liwan
W VOLUME THREE 2026: THE POP ISSUE

English
king baby ⋆。°✩ retweetledi
king baby ⋆。°✩ retweetledi
king baby ⋆。°✩ retweetledi
king baby ⋆。°✩ retweetledi
king baby ⋆。°✩ retweetledi
king baby ⋆。°✩ retweetledi


















